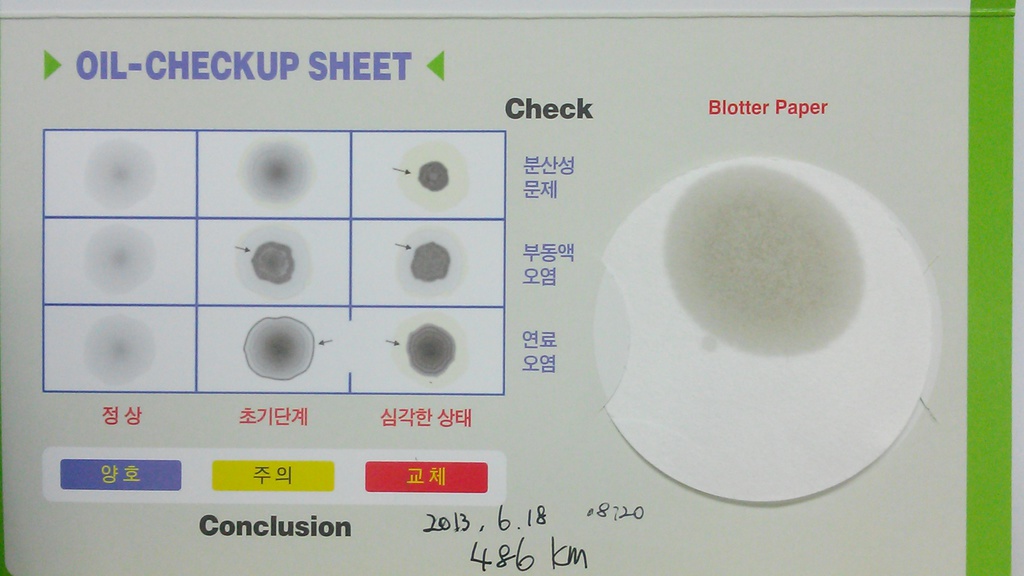

[¿¢¼¾Æ® 1.6VGTµðÁ© 2012] ºí·Ô½ºÆÌ ´Ù½Ã#1
![]() |
Á¤ÀçÈÆ|¹Ð¹ö±×
2013-06-18 11:30 ´ñ±Û:8 ÀÐÀ½:4576 22665Æ÷ÀÎÆ® 17°Ô½Ã±Û 78´ñ±Û ÃßõÇÑ±Û 4 |

| Â÷Á¾¹×³â½Ä | ¿¢¼¾Æ®1.6 µðÁ© 2012 |
|---|---|
| ¿¬·á | µðÁ© |
| ÃÑÁÖÇà°Å¸® | 486km |
| ¿ÀÀϱ³È¯ÈÄÁÖÇà°Å¸® | ½ÅÂ÷ (ÇØ´ç»çÇ×¾øÀ½) |
| ¿ÀÀÏÁ¾·ù | ½ÅÂ÷ (°øÀåÃâ°í ¿ÀÀÏ) |
| ÁÖÇà¿©°Ç | °í¼Óµµ·Î 70% , ½Ã³»ÁÖÇà 30% |
| ½Ã¿ëÈıâ | ¿£Áø¿ÀÀÏ Ä÷¸®Æ¼°¡ ³Ê¹« ±Ã±ÝÇØ¼ ½ÅÂ÷Ãâ°í 486km ¸¸¿¡ Å×½ºÆ® ÁøÇàÇÕ´Ï´Ù. ù µðÁ©ÀÌ´Ùº¸´Ï ¹¹°¡¹ºÁö Çϳªµµ ¸ð¸£°Ú³×¿ä. ¤¾¤¾ |
|
·Î¾âÆÛÇÃ|¯^0^
2013-06-18 11:38 1423831P |
|
Á¤ÀçÈÆ|¹Ð¹ö±×
2013-06-18 11:52 22665P |
|
·Î¾âÆÛÇÃ|¯^0^
2013-06-18 12:28 1423831P |



|
Á¤ÀçÈÆ|¹Ð¹ö±×
2013-06-18 13:32 22665P |
|
Á¤ÁöÈÆ|5050
2013-06-18 14:23 882971P |
|
Á¤ÀçÈÆ|¹Ð¹ö±×
2013-06-18 14:43 22665P |
070-8623-1234
Àϵµ»ê¾÷ÁÖ½Äȸ»ç | ´ëÇ¥ÀÚ : ±è¹Î¾Æ
ºÎ»ê±¤¿ª½Ã µ¿·¡±¸ ¾È¶ô2µ¿ 462-34 2F
»ç¾÷ÀÚµî·Ï¹øÈ£:607-81-84566
Åë½ÅÆÇ¸Å½Å°í¹øÈ£:Á¦2011-ºÎ»êµ¿·¡-0177È£
°³ÀÎÁ¤º¸º¸È£°ü¸®ÀÚ : ±è¹Î¾Æ
makim1010@naver.com
Copyright by ildo industry Co, Ltd.
PC¹öÀü
Á¤Ç°±¸¸Å¾È³»
¸â¹ö½Ê¾È³»